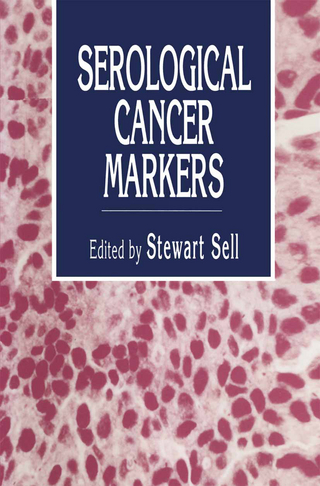
Serological Cancer Markers

Targeted Therapy and Multidisciplinary Care
Buch | Softcover
2014
|
Springer-Verlag New York Inc.
ISBN: 9781489982216
CHF 329,50 (inkl. MwSt)
- Versand in
10-15 Tagen